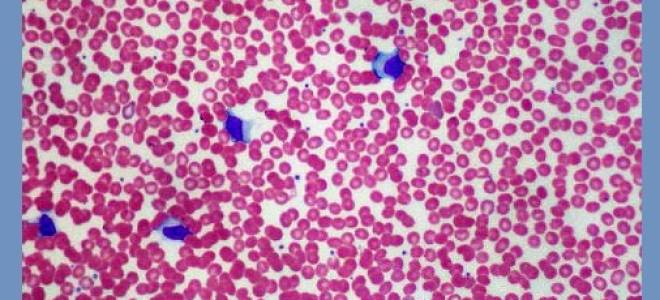
Лабораторная диагностика инфекционного лимфоцитоза — анализы

Другое
0
Лабораторная диагностика инфекционного лимфоцитоза — анализы Лабораторная диагностика инфекционного мононуклеоза Комплексное исследование для диагностики инфекционного мононуклеоза, включающее все необходимые серологические...

0
Медикаментозная гипотензивная терапия Алгоритм выбора препарата для лечения артериальной гипертонии *Импакт фактор за 2018 г. по данным РИНЦ Журнал входит...

0
Анализ на токсоплазмоз характеристика lgm отрицательного и lgm положительного Анализ на токсоплазмоз — характеристика lgm отрицательного и lgm положительного Важность...

0
Бланк общего анализа мочи когда выдают и кем Бланк общего анализа мочи: когда выдают и кем Каждый человек за свою...
0
Одышка при сердечной недостаточности — лечение О сердце Одышка — грозный симптом, часто возникающий при заболеваниях сердца. Что указывает на...
